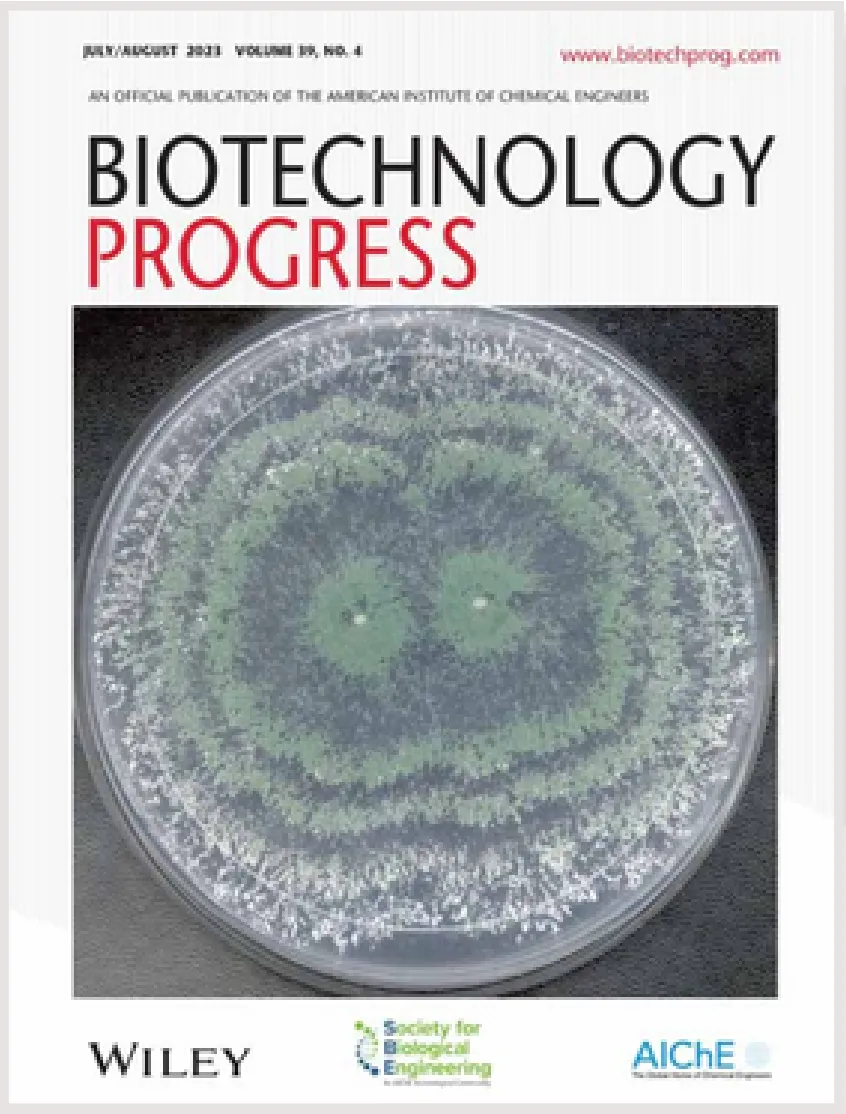

INTRODUCTION
Nucleases play a critical role in gene therapy and vaccine production by digesting extraneous genetic material. Their function in DNA clearance helps meet the stringent purity requirements of therapeutic products. DNA from host cells, considered an impurity, is typically removed by adding nucleases to the isotonic cell media. Salt can be added to prevent aggregation, which can improve accessibility of the host-cell DNA and simplify the downstream purification process.
Viral vector manufacturing
Viral vectors for gene therapy are most commonly manufactured in host cells. Host cells and vector type varies, but the framework of the manufacturing process is often similar.
- Transfection of host-cells with plasmids
- Production of viral vectors by host-cell
- Harvest of the viral vectors from supernatant and/or cell lysate
- Purification, formulation, sterile filtration and filling
Enveloped vs. non-enveloped vector
Viral vectors can be divided into two subclasses:
- Non-enveloped (e.g. Adenovirus, AAV)
- Lipid Enveloped (e.g. Lentivirus, Retrovirus)
Non-enveloped viruses are often more robust:
- Higher tolerance to additives as salt and detergents
- Allows lysis of host-cells to harvest also non-secreted vectors.
Something about viral vectors purification you may not know
This video shows SAN HQ /SAN HQ GMP’s increased nuclease activity as salt concentration rises leading to improved ability to clear DNA from viral vectors.
While this video shows the function of SAN HQ /SAN HQ GMP the same can be shown for M-SAN HQ. However, the primary difference is that M-SAN HQ reaches 100% nuclease activity at 200 mM.
I
NaCl
Why Salt Active Nucleases Are Vital to Biopharmaceutical Manufacturing
Nucleases play a critical role in gene therapy and vaccine production by digesting extraneous genetic material. Their function in DNA clearance helps meet the stringent purity requirements of therapeutic products. DNA from host cells, considered an impurity, is typically removed by adding nucleases to the isotonic cell media. Salt can be added to prevent aggregation, which can improve accessibility of the host-cell DNA and simplify the downstream purification process.
Yet, a misconception persists: salt is seen as a bioprocessing hindrance rather than an asset. We aim to demonstrate how salt is an underestimated catalyst in the quest to gain greater control and efficiency in your bioprocessing workflow.
Ask yourself: why adapt your process to the nuclease when you can adapt the nuclease to your process?
By customizing the nuclease to fit these high salt environments, you can gain not only greater control and efficiency but also achieve higher purity, reduced interference, and enhanced cost-effectiveness with less nuclease used.
As you increase salt concentration to optimum levels,conditions for DNA clearance improve, but enzymefunction decreases. This is a paradox that ArcticZymes effectively resolves by maintaining robust enzymaticactivity where it matters most.
Imagine, choosing the nuclease that performs best, based on your conditions and your process. This improves:
overall product quality, workflow simplification, and efficiency of DNA removal from your lysates or supernatant in a single step.
These specialized nucleases are a paradigm shift in the current landscape of available endonucleases for viral bioprocessing.

SAN HQ and M-SAN HQ demonstrate high activity levels adapted to relevant salinity. In contrast, Benzonase and Denarase show diminished activity as salt concentration increases. The data provides insights into the salt-tolerance capabilities of these nucleases, crucial for optimizing bioprocessing workflows.
Products referenced in Nuclease Activity vs Salt, Fig.1.
- M-SAN HQ : Optimal for the isotonic / physiological salinity found in cell media
- SAN HQ : Salt-loving nuclease optimal when increasing salt beyond isotonic.
- SAN HQ GMP - The only GMP grade Salt-Active Nuclease and is expected available from late Q4 2023 to help therapeutic products meet regulatory guidelines. SAN HQ GMP is the biochemically identical nuclease to SAN HQ but produced under GMP conditions.
More about product offering in
Solutions / Selection
When compared with non-salt-tolerant endonucleases (Benzonase® and DENARASE®), salt-tolerant endonucleases Relative Activity of M-SAN HQ vs. pH have better performance at the salt concentrations and pH naturally present in the cell culture supernatant, allowing its direct application without further processing. In addition to that, salt-tolerant endonucleases allowed the removal of chromatin, one of the most critical impurities and often overlooked in enveloped virus DSP.
- Mayer et al, Biotechnology Progress, First published: 27 March 2023, DOI:(10.1002/btpr.3342)
CHALLENGES
If you're reading this, you probably already know Bioprocessing is filled with challenges. We solve these with innovative solutions that improve your results, tackling challenges such as:
But first, it's vital to understand a common denominator in these problems that ties back to Biopharma's untapped potential:
The barrier to higher performance.
The Problem: Conventional nucleases lose their ability to bind or cleave DNA at physiological salt and above.

Fragile vectors like Lentiviruses are typically keptat the physiological salt range found in cell media.

Adenoviruses and AAV’s are examples of robust viral vectors prone to aggregation. Employing elevated salt concentration prevents aggregation and makes DNA more accessible for digestion.

Conventional nucleases have decreased function at cell media salt levels, and are near nonfunctional at de-aggregating levels of salt.
THE CONSEQUENCES: By not utilizing salt-adapted nucleases in high-salt conditions, biopharmaceutical manufacturers miss out on key advantages including:
- Increased purity
- Reduced costs
- Streamlined workflow
THE SOLUTION: We developed nucleases that thrive at the salt levels most relevant in bioprocessing; directly in cell media or at de-aggregating salt levels.

M-SAN HQ:
a nuclease optimized for the physiological salt range found in cell media, between 125-200 mM.

SAN HQ/SAN HQ GMP:
a nuclease optimized for high salt, enhancing its DNA-clearing functionality as salt levels rise above 300 mM.
The Challenge in Removing Host Cell Chromatin Impurities
In bioprocessing, the primary role of a nuclease is to efficiently digest and fragment host-cell DNA into sufficiently small pieces, facilitating its removal during downstream processing. While most nucleases can effectively degrade naked DNA into tiny fragments under optimal conditions—as demonstrated by M-SAN HQ and SAN HQ, which can digest dsDNA into fragments smaller than 8 nt—the reality in bioprocessing is more complex.
The DNA targeted for removal often exists as chromatin, embedded in a complex matrix containing remnants of the lysed host cell as well as large amounts of the therapeutic product. The product may or may not have an affinity for the chromatin you aim to remove.
High salt is often applied to mitigate issues like aggregation. The real challenge lies in a nuclease's ability to efficiently fragment chromatin under these more complicated, high-salt, conditions—not merely degrading naked DNA under ideal circumstances.
Many researchers and bioprocess engineers are not aware that host cell DNA is present in the form of chromatin associated with histones. In the presence of salt, chromatin opens and becomes better accessible for a nuclease. Therefore, it is obvious for me that a salt tolerant nuclease does a much better job in digesting DNA.”
- Professor Alois Jungbauer, University of Natural Resources and Life Sciences, Vienna
Discover how Mayer et al. employed ArcticZymes nucleases to break down chromatin into DNA fragments small enough for effective flow-through purification, achieving unprecedented purity levels.
How to reduce residual DNA from the manufacturing process
Residues from the manufacturing process must be below strict limits for products administered to humans, so it is imperative to understand the mechanisms for reducing and detecting these residues to ensure safety and compliance.
SAN HQ is effective at reducing residual DNA because it effectively degrades Chromatin DNA to sizes that can be fully trapped and removed during purification, ensuring compliance with strict regulatory criteria.
- Regulatory Compliance: SAN HQ facilitates digestion of residual DNA, aiding in compliance with FDA standards. SAN HQ GMP offers an additional layer of regulatory assurance.
- Product Safety: SAN HQ minimizes contaminating host cell residual DNA, enhancing the safety profile of gene therapy products.
- Product Purity: By reducing residual DNA, SAN HQ improves product purity.
- Efficiency: Streamlines downstream purification by reducing DNA-induced viscosity challenges.
- Product Quality: Ensures the final product primarily consists of therapeutic viral vectors for consistent, high-quality outcomes.
The Big Picture
Reducing residual DNA in lysate is not a procedural step; it's a regulatory must-do that directly impacts product quality and safety.
Why It Matters
Effective DNA clearance not only ensures AAV vector purity but also minimizes patient risk. It's not just about compliance; it's about advancing the quality of gene therapy.
The Bottom Line
DNA clearance is non-negotiable for compliance, safety, and market success
Given its optimal activity in high salt conditions, SAN HQ improves downstream processes and reduces purification time without loss of vector yield and activity. SAN HQ’s improved efficiency is serotype independent.
- Evaluation by a viral vector core lab at a major academic center in mid-Atlantic region (US)

Material was sampled both before and after endonuclease treatment (at 37°C for 1 hr) at optimum buffer conditions. Genomic DNA was quantified using the Quant-iT dsDNA High Sensitivity Assay Kit (Invitrogen) and normalized to pre-enzyme treatment samples.
SOLUTIONS / SELECTIONS
We turn your challenges into advantages
For enzymatic removal of DNA impurities in bioprocessing we developed M-SAN HQ and SAN HQ to use what was previously an obstacle into achieving a revolution in cleaner viral vectors, or protein-based therapeutic products.
These novel nucleases maximize results at your optimum salt levels, instead of being inhibited by them.
See below for “Products at a Glance” or click each for complete details including:
Product overview | Performance data & figures | Specifications | Documents | FAQs |Ordering Info | Protocols | Publications.
Optimal for the physiological salinity in cell media.
Salt tolerant nucleases optimal with salt beyond isotonic.
Nucleases Optimized for Your Preferred Salt Levels.
In the simplicity of nature, we find the grandest of designs.
- Fridtjof Nansen, Norwegian Polar Explorer, Scientist, and Nobel Laureate

Products at a glance:
Brief overview of nucleases for bioprocessing workflows. Click each for complete details including: Product overview | Performance data & figures | Specifications | Documents | FAQs |Ordering Info | Protocols | Publications.
M-SAN HQ: No Other Endonuclease Performs Better at Physiological Conditions
Medium-Salt Active Nuclease High Quality (M-SAN HQ) is a bioprocessing grade nuclease developed for removal of both single and double stranded DNA and RNA, at the physiological salt conditions most often used in bioprocessing and biomanufacturing workflows. M-SAN HQ allows you to directly replace Benzonase without changing your workflow.
SAN HQ: The Ultimate Solution for DNA Clearance in Adenovirus & AAV Bioprocessing
Salt Active Nuclease High Quality (SAN HQ) and SAN HQ GMP are bioprocessing grade nucleases developed as the most efficient solution for removal of nucleic acids, at high salt conditions. This nonspecific endonuclease has peak activity at salt concentrations between 400 – 650 mM
Optimized for high-salt environments, SAN HQ ensures unparalleled DNA removal without compromising the integrity of robust viral vectors.
SAN High Quality 2.0
SAN High Quality 2.0 is an alternative version of our SAN HQ enzyme. The primary difference with SAN HQ 2.0 is its easier removal and wider compatibility with downstream processes used in bioprocessing workflows while exhibiting the same salt tolerance and other biochemical characteristics as SAN HQ. Its’ pI of 9.6 allows removal via IEX chromatography.
The downstream compatibility improvements are of particular importance if used with an ionic exchange media or using size exclusion chromatography / TFF below 100 kDa pore size.
CASE STUDY
Superior Chromatin digestion before flow through Purification
In a study by Mayer et al. (2023), the use of four different nucleases were evaluated in combination with a flow-through (FT) purification chromatography method for measles viruses. The supernatant was nuclease treated prior to the FT column purification (Load) to remove DNA impurities from the viral vectors. Smaller impurities, like DNA fragments, will bind to the resin in the FT column, while the larger virus pass through and are collected in the flow-through. To evaluate the efficiency of chromatin removal, host chromatin (histone H3) was measured using western blot, shown below.
The study clearly demonstrated that M-SAN HQ and SAN HQ efficiently degrade DNA to fragments sufficiently small for capturing by the resin, resulting in no detected chromatin in the flow-through under all tested salt conditions, as shown by lack of band in the FT, (marked with green arrows). In contrast, for the two competitor nucleases, a clear histone H3 band is detected in the flow-through, indicating insufficient chromatin removal (marked with white arrows).

Western blots detecting viral vectors (nucleoprotein, top) and chromatin (histone H3 protein, bottom) (SN, supernatant; SN*, high salt supernatant, Load, supernatant after nuclease digestion; FT, flow-through; W, wash; E, elution). Mayer et al, Biotechnology Progress, First published: 27 March 2023,DOI:(10.1002/btpr.3342)
Our salt active nucleases digest DNA faster and create smaller fragments.
Why it matters:
- ArcticZymes nucleases enable improved Flow-Through Purification: Due to smaller DNA fragment size
- Process simplification: Reduces the need for an additional purification step
- Reduced time, reduced costs
ArcticZymes nucleases are ideal for Flow-Through Purification

QUALITY
Quality Documentation
ArcticZymes is dedicated to the quality of its products and is certified according to ISO 13485.
High Purity and High Quality: As the original manufacturer of SAN HQ and M-SANHQ nucleases, we offer full traceability of the supply chain and manufacturing process. We also assist our clients in implementing necessary identity and quality assays in-house
Our nucleases are manufactured according to ISO 13485.
In addition, relevant cGMP requirements have been implemented and the products are qualified for use by GMP-compliant customers.
The nucleases are manufactured using only non-animal origin raw materials to minimize the risk of contamination with adventitious agents.
Our manufacturing site in Norway is regularly audited by our customers.
ArcticZymes ELISA kits are used with salt active nucleases to detect residual enzyme(s).
Accreditation & Quality Assurance:
Examples of documentation available:
- Elemental Impurities Statement
- Residual Solvent Statement
- TSE-BSE Statement
- Latex Statement
- Allergen Certificate
- Aflatoxin Certificate
- Melamine Certificate
- GMO Certificate
- Bioburden (TYMC/TAMC)
- Endotoxin assays (EP)
- Toxicological Risk Assessment
M-SAN HQ, SAN HQ/SAN HQ GMP
The ELISA kits for either SAN HQ/SAN HQ GMP or M-SAN HQ utilize a classical sandwich ELISA methodology and are designed to detect and quantify residual levels of your nuclease of choice, ensuring that you meet rigorous quality standards in both final products and in-process samples.
WHY ARCTICZYMES
Our research resulted in the first Salt Active Nuclease for use in Biopharmaceutical manufacturing in 2017.
By aligning with the optimal salt balance for host cells, these nucleases enhance both vitality and efficient DNA clearance. Have we explained how salt was an obstacle before? The result is a streamlined workflow, improved product quality, and a new frontier in bioprocessing efficiency.
We continue to develop nucleases that out-perform rivals and that empower you to choose the nuclease that performs best, based on your conditions and your process.
As scientists focused on the challenge of maximizing DNA clearance we put ourselves in your shoes and asked:
What if... the nuclease was designed for your ideal saline conditions, rather than you bending your process to fit the enzyme?
years of experience in the gobal market
We are certified according to
quality standard.
Our novel enzymes help you to
your technology.
Our unique access to
keeps growing thanks to new labs and new experts.
We have been driven for over 30 years by a singular focus on enzymes, attracting like-minded scientists who share our zeal for excellence and innovation in this specialized field, Working closely with customers, we create innovative solutions that elevate their products from good to great, ultimately enabling them to achieve their goals and redefine the boundaries of biopharmaceutical manufacturing.







